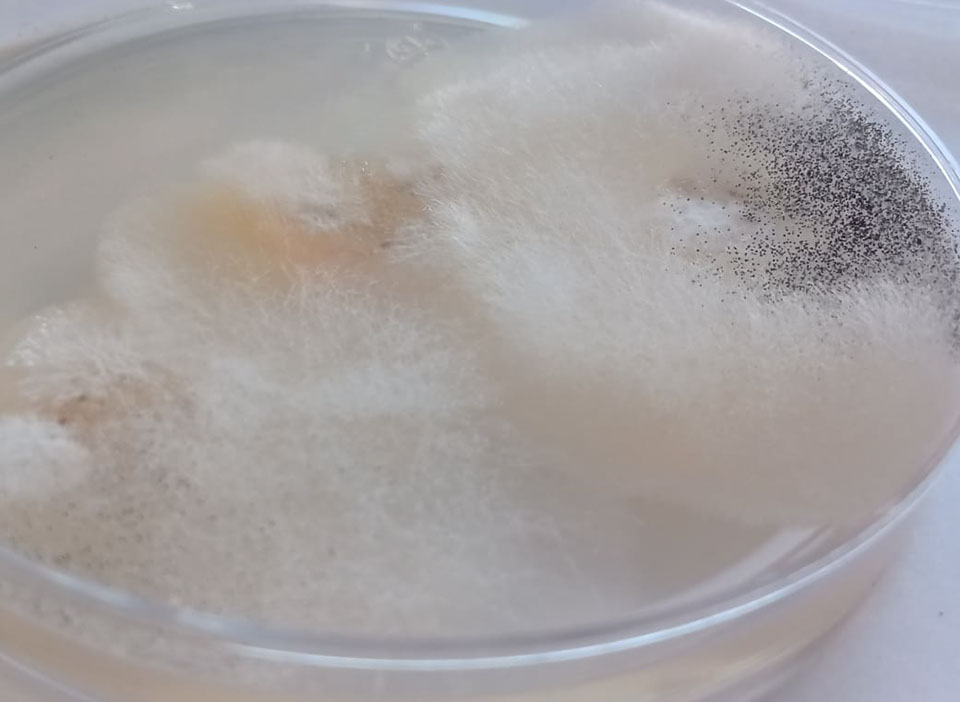
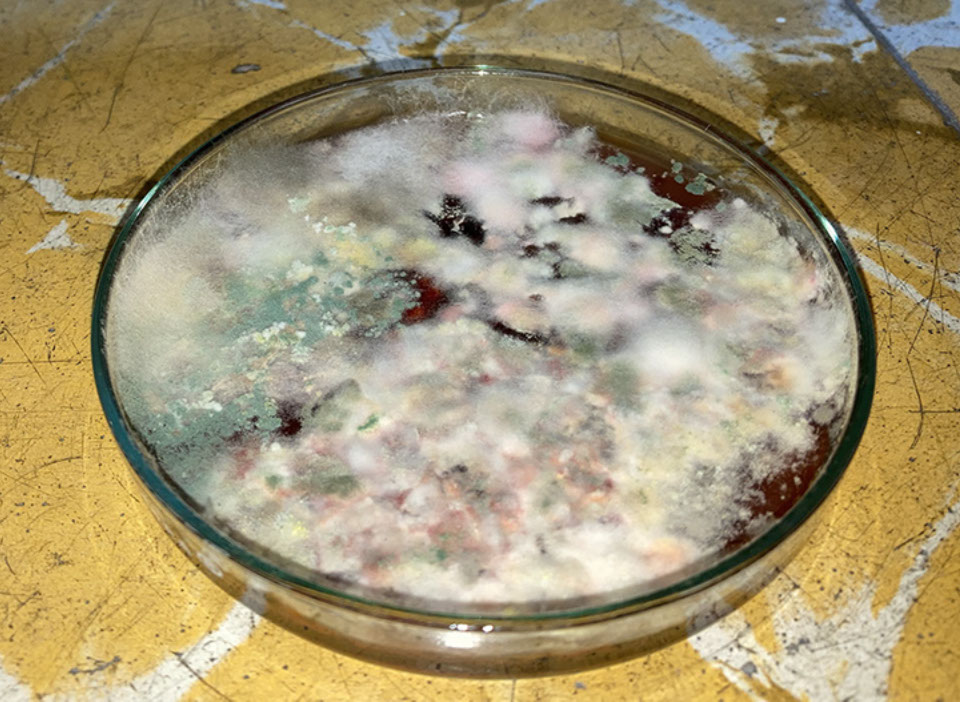
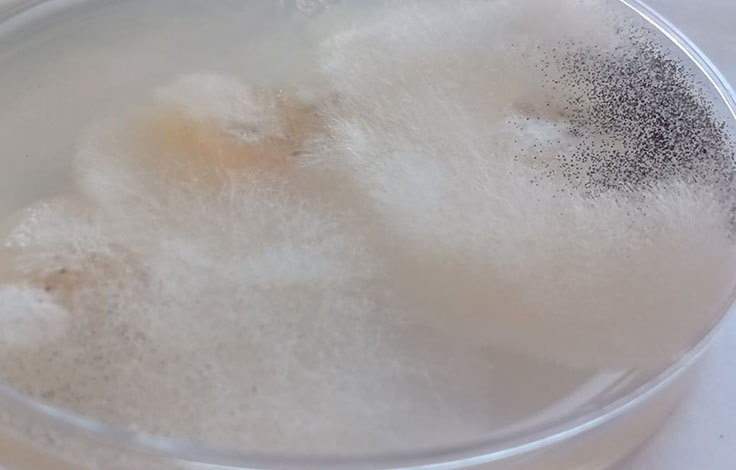
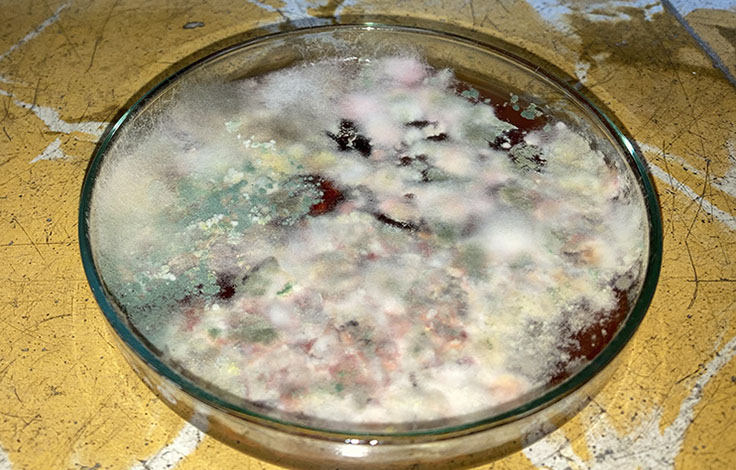

ANTINATURAL SELECTION
Workshop: Transhumanism, Molecular Biology and Art




This workshop had among its objectives the better understanding of molecular biology and biotechnologies by a group mainly made up of artists, also the appropriation and practice of techniques from biohacking or DIY biology, the analysis of different fictional storytelling and review of bioart works were proposed as a starting point for reflection and speculative design around the possible consequences of the use of certain technologies. The workshop took place daily for 8 weeks (a total of 80 ours) and resulted on a rich conversation around what issues may bioart approach and how (technically speaking).
The program covered the following subjects:
- Research in Art and Science
-
Molecular Biology (and why it is not biotechnology)
- What are biomolecules?
- Definition and history of Bioart
-
DNA and RNA
- Genes and genetic code
- Protein synthesis
- How to explore a genome
- DNA and art
- Vectors for genetic information
-
Biohacking and molecular biology
- Art and biohacking
- Mutation and evolution
- Biopolitics
-
- An approach from facts
- An approach from fiction
Practices:
- Home DNA extraction
- Coding (and writing) with proteins
- Glitch art and genetic code
- Design your medium for fungus culture
- Home made microscope
- Sketching a proyect